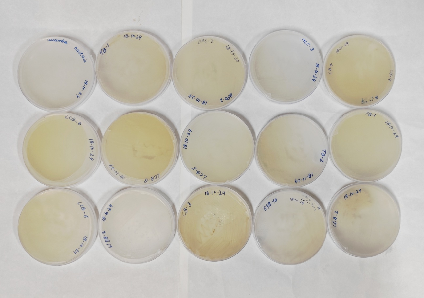

|
Technology Details
- CISH- Decomposer contains plant growth promoting organic residue into very simple compounds that are easily absorbed by the plants including 17 microorganisms.
- One liter of each microorganisms to be sprinkled on tough organic substrate (100 kg) including mango peel, mango leaves lawn grass and field residues at one week interval.
- Compost will be ready within one month with high N, P, and K value than FYM.
Licensing terms :
- License fee : Rs. 62,000 +applicable taxes
- Licensing territory : India
- Royalty : 5 % on net-invoice value
Target customers : Startups, MSMEs, Industries
